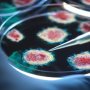

بسبب إنفلونزا الطيور.. الحكومة الأميركية تأمر باختبار الألبان

تخطط الولايات المتحدة في 16 ديسمبر الجاري لبدأ اختبار إمدادات الحليب الخام في جميع أنحاء البلاد للكشف عن وجود فيروس أنفلونزا الطيور شديد العدوى الذي انتشر بين الأبقار الحلوب.
وقالت وزارة الزراعة إنه يجب اختبار اللبن الخام أو غير المبستر من مزارع الألبان ومراكز معالجتها بجميع أنحاء البلاد عند الطلب اعتبارا من 16 ديسمبر/كانون الأول. وسيبدأ الاختبار في 6 ولايات هي كاليفورنيا وكولورادو وميشيغان وميسيسيبي وأوريجون وبنسلفانيا.
وقال مسؤولون إن هذه الخطوة تهدف إلى "احتواء والقضاء في نهاية المطاف على الفيروس"، المعروف باسم "إيه إتش5 إن1″، والذي تم اكتشافه لأول مرة في مارس/آذار في الأبقار الحلوب في الولايات المتحدة. ومنذ ذلك الحين، تأكدت إصابة أكثر من 700 قطيع بالولايات المتحدة في 15 ولاية.
وقال وزير الزراعة توم فيلساك في بيان: "سيمنح هذا المزارعين وعمال المزارع ثقة أفضل في سلامة حيواناتهم وقدرتهم على حماية أنفسهم، وسيضعنا على طريق السيطرة بسرعة على الفيروس ووقف انتشاره في جميع أنحاء البلاد".
وقال مسؤولو الصحة إن خطر إصابة البشر بإنفلونزا الطيور لا يزال منخفضا، حيث إن البسترة أو المعالجة الحرارية، تقتل الفيروس في اللبن، وتجعله آمنا للشرب.
للمزيد تابع خليجيون نيوز على: فيسبوك | إكس | يوتيوب | إنستغرام | تيك توك